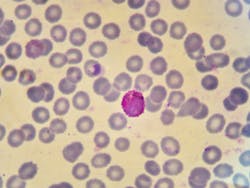
656a1352704454001e01baa4 Dreamstime 99829516 656a1352704454001e01baa4 Dreamstime 99829516

WHO’s annual malaria report spotlights the growing threat of climate change
Despite strides in expanding access to insecticide-treated nets and medicines to help prevent malaria in young children and pregnant women, more people were getting sick with malaria, according to a new report published by the World Health Organization (WHO).
In 2022, there were estimated 249 million malaria cases globally, exceeding the pre-pandemic level of 233 million in 2019 by 16 million cases. In addition to the disruptions caused by COVID-19, the global malaria response has faced a growing number of threats, such as drug and insecticide resistance, humanitarian crises, resource constraints, climate change impacts and delays in program implementation particularly in countries with a high burden of the disease.
The 2023 World malaria report delves into the nexus between climate change and malaria. Changes in temperature, humidity and rainfall can influence the behavior and survival of the malaria-carrying Anopheles mosquito. Extreme weather events, such as heatwaves and flooding, can also directly impact transmission and disease burden. Catastrophic flooding in Pakistan in 2022, for example, led to a five-fold increase in malaria cases in the country.
Climate variability is expected to have indirect effects on malaria trends through, for example, reduced access to essential malaria services and disruptions to the supply chain of insecticide-treated nets, medicines and vaccines. Population displacement due to climate-induced factors may also lead to increased malaria as individuals without immunity migrate to endemic areas.
Data on the long-term impact of climate change on malaria transmission is sparse. However, the direction and magnitude of any impacts are likely to vary across social and ecological systems, both within and between countries.
The COVID-19 pandemic significantly disrupted malaria services, leading to a surge in both incidence and mortality rates, exacerbating already stalled progress against the disease.
Globally there were an additional five million malaria cases in 2022 over the previous year and five countries bore the brunt of these increases. Pakistan saw the largest increase, with about 2.6 million cases in 2022 compared to 500 000 in 2021. Significant increases were also observed in Ethiopia, Nigeria, Papua New Guinea and Uganda.
Meanwhile, in the 11 countries that carry the highest burden of malaria, rates of new infections and deaths have levelled off following an initial upsurge during the first year of the pandemic. These countries, supported through the WHO “High burden to high impact” approach, saw an estimated 167 million malaria cases and 426 000 deaths in 2022. In view of current trends, progress towards critical 2025 milestones of the WHO global malaria strategy is off track by a wide margin.
The report also cites achievements such as the phased roll-out of the first WHO-recommended malaria vaccine, RTS,S/AS01, in three African countries. A rigorous evaluation has shown a substantial reduction in severe malaria and a 13% drop in early childhood deaths from all causes in the areas where the vaccine has been administered compared with areas where the vaccine was not introduced.
There has also been progress toward malaria elimination in many countries with a low burden of the disease. In 2022, 34 countries reported fewer than 1000 cases of malaria compared to just 13 countries in 2000. This year alone, three more countries were certified by WHO as malaria-free – Azerbaijan, Belize and Tajikistan – and several others are on track to eliminate the disease in the coming year.